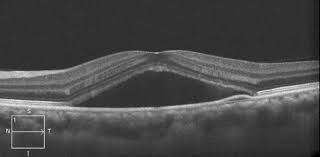
Hình 2

Từ tên gọi của bệnh, bạn đã có thể hình dung ra bệnh có liên quan đến cả võng mạc, hắc mạc và ảnh hưởng đến vùng võng mạc trung tâm. Đây là tình trạng bệnh lý có hiện tượng bong thanh dịch của võng mạc do rò dịch từ mao mạch hắc mạc qua lớp biểu mô sắc tố của võng mạc. Bệnh thường tự giới hạn ở vùng hoàng điểm nên bạn có thể nhận biết bệnh rất nhanh và rõ ràng với các dấu hiệu như: nhìn mờ, nhìn hình nhỏ hơn so với bình thường, nhìn hình bị méo và biến dạng. Tuy bệnh này có tính chất lành tính nhưng cần phải phân biệt với các nguyên nhân nguy hiểm khác cũng gây tình trạng rò dịch qua lớp biểu mô sắc tố võng mạc như tân mạch hắc mạc, viêm và khối u.

Bệnh được chia thành 2 hình thái lâm sàng: (1) Hình thái điển hình với 1 hoặc nhiều điểm rò dịch ở lớp biểu mô sắc tố võng mạc; (2) Hình thái mạn tính hay còn gọi là bệnh biểu mô sắc tố võng mạc toả lan biểu hiện là bong thanh dịch võng mạc kèm theo teo lớp biểu mô sắc tố và lắng đọng sắc tố. Để chẩn đoán xác định bệnh và hình thái lâm sàng của bệnh ngoài việc khám lâm sàng thì chụp mạch ký huỳnh quan là vô cùng cần thiết.
Ai là người có nguy cơ bị bệnh?
Bệnh thường gặp ở độ tuổi từ 20-55, nam giới cao gấp 6 lần so với nữ giới. Bệnh đặc biệt có liên quan với yếu tố tâm lý như stress, người có nhân cách typ A, mất ngủ kéo dài; hoặc có tình trạng bệnh lý phải sử dụng corticosteroid, tăng huyết áp, cơn ngừng thở khi ngủ. Một số nghiên cứu đưa ra mối liên quan giữa Helicobacter pylori (vi khuẩn gây bệnh viêm loét dạ dày) và bệnh hắc võng trung tâm thanh dịch với 78% nhiễm H. pylori ở nhóm bị bệnh hắc võng mạc trung tâm thanh dịch so với 43,5% ở nhóm đối chứng.

Tiến triển của bệnh như thế nào?
Tiên lượng của bệnh hắc võng mạc trung tâm thanh dịch tương đối tốt. 90% bệnh nhân có thể đạt thị lực như trước khi bị bệnh. Tuy nhiên bệnh hắc võng mạc trung tâm thanh dịch thể mạn tính thì tiên lượng thị lực kém hơn vì có tổn thương lớp biểu mô sắc tố toả lan.
Bệnh tuy có tiên lượng tốt nhưng tỷ lệ tái phát lại lên đến 40-50% và 5% trường hợp có biến chứng tân mạch hắc mạc.

Nếu điều trị bệnh có thể khỏi không?
Bạn không nên quá lo lắng vì bệnh này tương đối lành tính, có thể khỏi và không để lại di chứng gì. Bạn cần phải nghỉ ngơi, tránh những yếu tố nguy cơ như: các chất kích thích, rượu, bia, thuốc lá, cafe, tránh căng thẳng thần kinh, mất ngủ. Bạn có thể lựa chọn các hoạt động thể thao tĩnh như câu cá, yoga.
Bác sĩ sẽ kê đơn thuốc điều trị cho bạn nhưng bạn cũng cần theo dõi và khám lại định kỳ theo hẹn để phát hiện sớm nếu bệnh tái phát hoặc có biến chứng tân mạch hắc mạc.
Trường hợp bệnh hay tái phát và kéo dài, giảm thị lực nhiều và ảnh hưởng đến cuộc sống của bạn, bác sĩ có thể tiến hành laser điểm dò dịch.
Nếu có biến chứng tân mạch hắc mạc thì cần điều trị bằng tiêm các thuốc anti-VEGF.
